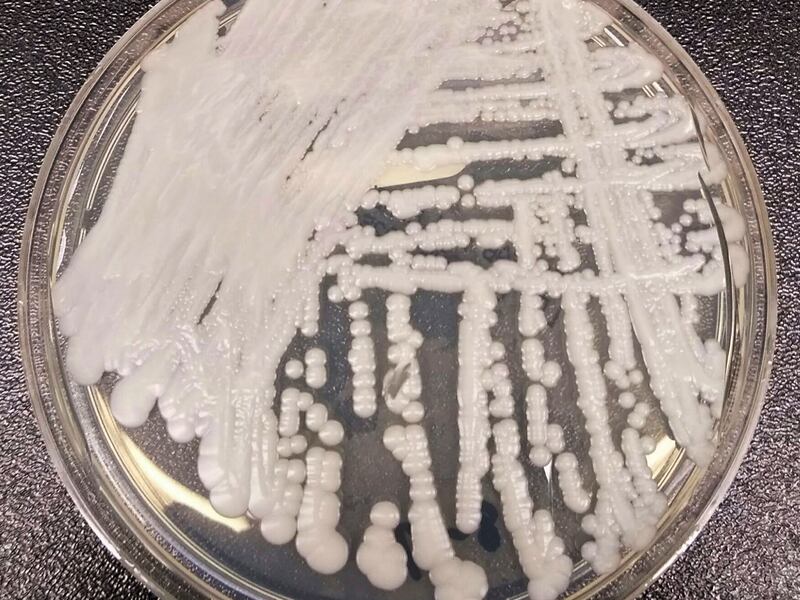
A strain of Candida auris cultured in a petri dish at a CDC laboratory.

The World Health Organization published a list of 19 fungi that present the greatest risk to human health. This announcement is a response to the increased threat such fungi pose, which kill roughly 1.3 million people a year and contribute to 5 million other deaths each year, the health agency reports.
At least 7,000 people in the United States died from fungal infections last year, the CDC reported, per The Wall Street Journal.
“Fungi are the ‘forgotten’ infectious disease. They cause devastating illnesses but have been neglected so long that we barely understand the size of the problem,” said Dr. Justin Beardsley, of the University of Sydney Infectious Diseases Institute, who also led the WHO Fungal Priority Pathogens List’s study group.
Invasive fungal diseases present a particular threat to the immunocompromised. Those at the greatest risk of deaths by fungal diseases are individuals with cancer, HIV/AIDS, tuberculosis, organ transplants and other underlying health conditions.
The COVID-19 pandemic also led to an increase in fungal infections among hospitalized patients, according to WHO. In India, Mucormycosis, or “the black fungus,” targeted many COVID-19 patients, many of whom required facial surgeries to remove the disease, The New York Times reported.
Fungal diseases have become particularly dangerous since they have developed a resistance to treatment.
The aim of the health organization’s announcement is to draw attention to the depth of this risk. Deadly fungi is microscopic and goes undetected by the human eye. There is scarce data on fungal infections, a lack of resources and diagnostic tools and minimal attention — especially in poorer countries. The WHO blames the shortage of information on fungal infections for the high death toll.
WHO hopes its message will come as a call to action to healthcare workers, governments and drug researchers across the world.
“The exact burden of fungal diseases and antifungal resistance, are unknown, and the response is therefore undermined,” the health agency said in a news release.
What are the deadly fungi?
The health organization’s list of priority fungi is broken down into three categories from the most dangerous listed at “critical” to high and medium priority.
The “critical” group, which WHO considers the most dangerous fungi, contains four types of fungal pathogens: Cryptococcus neoformans, Aspergillus fumigatus, Candida albicans and Candida auris. The high group contains seven pathogens, and the medium contains eight.
The priority list of fungal species includes fungi, yeasts and molds.
“These fungal infections, when you get them, it’s not from another person, you get them from the environment,” said Michelle Momany, a fungal researcher at the University of Georgia, per NPR.
Fungal infections become increasingly dangerous once they enter the bloodstream and internal organs, according to The New York Times. Infections from fungal pathogens can present themselves in a series of symptoms depending on the type of fungus.
Cryptococcus neoformans infections from the high priority group can cause neck pain, nausea and headaches. Infections from the yeast Candida auris can cause fever and chills.
WHO’s call to action
The WHO presented a three-part plan of action:
- “Strengthening laboratory capacity and surveillance.”
- “Sustaining investments in research, development and innovation.”
- “Enhancing public health interventions for prevention and control.”
“Countries are encouraged to follow a stepwise approach, starting with strengthening their fungal disease laboratory and surveillance capacities, and ensuring equitable access to existing quality therapeutics and diagnostics, globally,” Dr. Haileyesus Getahun, WHO director in the AMR Global Coordination Department, said.